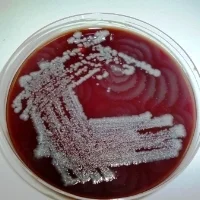

Former Graduate Students
Michelle Wang
Khyle Richards-Corke
Min Woo Bae
Xueyang Dong
Amelia Woo
Joel Wong
Devon Van Cura
Anne Marie Crooke
Paula Pelayo
Duncan Kountz
Beverly Fu
Matt Volpe
Nathaniel Braffman
Stephania Irwin
Doug Kenny
Teresa Martins
Vayu Maini Rekdal
Tai Ng
Carina Chittim
Marina Orman
Ben Schneider
Ben Levin
Yolanda Huang
Li Zha
Abraham Waldman
Nitzan Koppel
Samantha Cassell
Ethan Winter
Hitomi Nakamura
Smaranda Bodea
Carolyn Brotherton
Alex Sieg
Hillary Hamer
Former Postdoctoral Fellows
Joscha Meiers
Antonio Tinoco Valencia
Jared Mayers
Grace Kenney
Martin Daniel-Ivad
Erik Carlson
Chip Le
Justin Silpe
Nate Glasser
Lauren Rajakovich
Monica McCallum
Maud Bollenbach
Yindi Jiang
Ben Woolston
Walter Sandoval
Michael Luescher
Paul Boudreau
Lihan Zhang
Matt Wilson
Spencer Peck
Ana Martinez del Campo
Erica Schultz
Peng Wang
Stephen Wallace
Pedro Leão
Kristen Seim
Gopal Sirasani
Yunmi Lee
Former Lab Managers
Operations
Carmen Oleaga Quintas
Former Research Staff
Anna Barrow
Alison Wong
Vince Nieto
Former Visiting Scholars